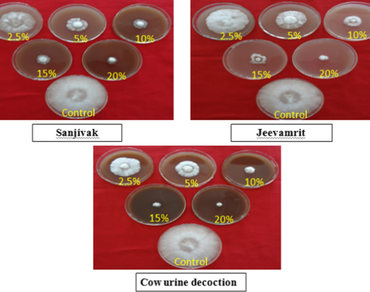
Eco-friendly management of white root rot (Dematophora necatrix, Hartig) of apple with selected organic formulations in Himachal Pradesh, India

Vol 36 Issue 2, June 2023
Total Articles: 44

Differential biochemical response of basmati and non-basmati rice seeds upon bakanae (Fusarium fujikuroi) infection
Research Articles
Views: 3676
Pages: 516-525
Published: 07 June, 2022
Doi: 10.1007/s42535-022-00411-5

Phorophytic characteristics of Eucalyptus globulus: comparing trees with and without epiphytes
Research Articles
Views: 3947
Pages: 526-533
Published: 08 June, 2022
Doi: 10.1007/s42535-022-00403-5

Chemical composition and antimicrobial activity of Teucrium luteum subsp. flavovirens essential oil from Northwestern Algeria
Research Articles
Views: 3953
Pages: 534-541
Published: 10 June, 2022
Doi: 10.1007/s42535-022-00387-2
Eco-friendly management of white root rot (Dematophora necatrix, Hartig) of apple with selected organic formulations in Himachal Pradesh, India
Research Articles
Views: 3900
Pages: 542-549
Published: 25 June, 2022
Doi: 10.1007/s42535-022-00394-3

Study of biochemical and biophysical adjustments during transition from desiccation-to-fully-hydrated states in Riccia gangetica and Semibarbula orientalis
Research Articles
Views: 3845
Pages: 550-558
Published: 27 June, 2022
Doi: 10.1007/s42535-022-00409-z

Phytochemical, antioxidant, and antimicrobial attributes of different extracts of seeds: the Algerian variety of dates ‘Deglet Nour’ (Phoenix dactylifera L.)
Research Articles
Views: 3634
Pages: 559-565
Published: 28 June, 2022
Doi: 10.1007/s42535-022-00413-3

Radish (Raphanus sativus L.) growth and gas exchange responses to exogenous ascorbic acid and irrigation levels
Research Articles
Views: 4407
Pages: 566-574
Published: 13 July, 2022
Doi: 10.1007/s42535-022-00422-2

Assessment of in vitro anti-inflammatory, antioxidant and antidiabetic activities of Solanum khasianum Clarke
Research Articles
Views: 3641
Pages: 575-582
Published: 13 July, 2022
Doi: 10.1007/s42535-022-00410-6

Habitat suitability modelling of Buxus wallichiana Bail.: an endemic tree species of Himalaya
Research Articles
Views: 3605
Pages: 583-590
Published: 14 July, 2022
Doi: 10.1007/s42535-022-00428-w